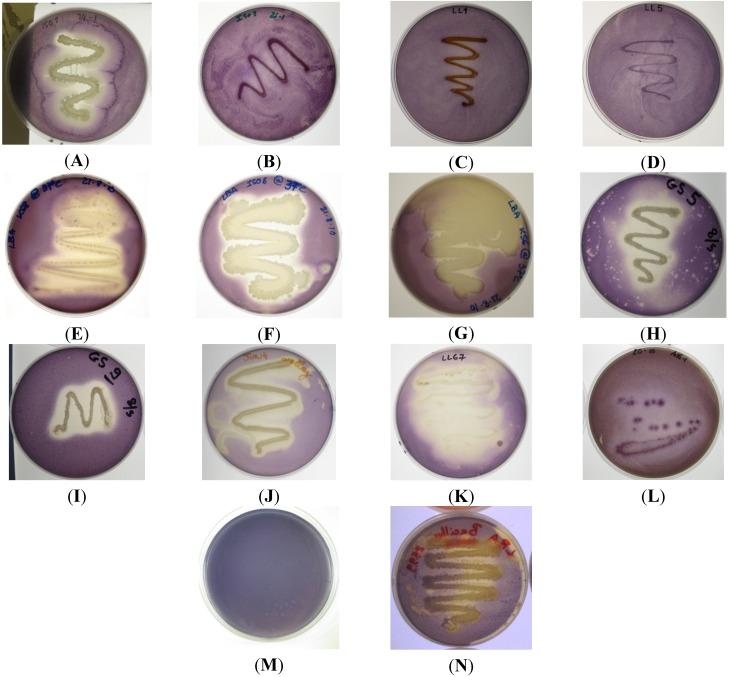
https://cdn.ncbi.nlm.nih.gov/pmc/blobs/01fe/4306922/182e2dca7ecb/marinedrugs-13-00001-g001.jpg

海洋来源的群体感应抑制活性增强了妥布霉素对铜绿假单胞菌的抗菌效果。
Marine-derived quorum-sensing inhibitory activities enhance the antibacterial efficacy of tobramycin against Pseudomonas aeruginosa.
作者信息
Busetti Alessandro, Shaw George, Megaw Julianne, Gorman Sean P, Maggs Christine A, Gilmore Brendan F
机构信息
School of Pharmacy, Queen's University Belfast, 97 Lisburn Rd, Belfast BT9 7BL, UK.
School of Biological Sciences, Medical Biology Center, 97 Lisburn Road, Belfast BT9 7BL, UK.
出版信息
Mar Drugs. 2014 Dec 24;13(1):1-28. doi: 10.3390/md13010001.
Bacterial epiphytes isolated from marine eukaryotes were screened for the production of quorum sensing inhibitory compounds (QSIs). Marine isolate KS8, identified as a Pseudoalteromonas sp., was found to display strong quorum sensing inhibitory (QSI) activity against acyl homoserine lactone (AHL)-based reporter strains Chromobacterium violaceum ATCC 12472 and CV026. KS8 supernatant significantly reduced biofilm biomass during biofilm formation (-63%) and in pre-established, mature P. aeruginosa PAO1 biofilms (-33%). KS8 supernatant also caused a 0.97-log reduction (-89%) and a 2-log reduction (-99%) in PAO1 biofilm viable counts in the biofilm formation assay and the biofilm eradication assay respectively. The crude organic extract of KS8 had a minimum inhibitory concentration (MIC) of 2 mg/mL against PAO1 but no minimum bactericidal concentration (MBC) was observed over the concentration range tested (MBC > 16 mg/mL). Sub-MIC concentrations (1 mg/mL) of KS8 crude organic extract significantly reduced the quorum sensing (QS)-dependent production of both pyoverdin and pyocyanin in P. aeruginosa PAO1 without affecting growth. A combinatorial approach using tobramycin and the crude organic extract at 1 mg/mL against planktonic P. aeruginosa PAO1 was found to increase the efficacy of tobramycin ten-fold, decreasing the MIC from 0.75 to 0.075 µg/mL. These data support the validity of approaches combining conventional antibiotic therapy with non-antibiotic compounds to improve the efficacy of current treatments.
从海洋真核生物中分离出的细菌附生植物被筛选用于产生群体感应抑制化合物(QSIs)。海洋分离株KS8被鉴定为假交替单胞菌属,发现其对基于酰基高丝氨酸内酯(AHL)的报告菌株紫色杆菌ATCC 12472和CV026表现出强烈的群体感应抑制(QSI)活性。KS8上清液在生物膜形成过程中显著降低了生物膜生物量(-63%),在预先形成的成熟铜绿假单胞菌PAO1生物膜中也降低了生物膜生物量(-33%)。在生物膜形成试验和生物膜清除试验中,KS8上清液还分别使PAO1生物膜活菌数减少了0.97个对数(-89%)和2个对数(-99%)。KS8的粗有机提取物对PAO1的最低抑菌浓度(MIC)为2 mg/mL,但在所测试的浓度范围内未观察到最低杀菌浓度(MBC)(MBC>16 mg/mL)。KS8粗有机提取物的亚MIC浓度(1 mg/mL)显著降低了铜绿假单胞菌PAO1中群体感应(QS)依赖性的绿脓菌素和绿脓青素的产生,而不影响生长。发现使用妥布霉素和1 mg/mL的粗有机提取物联合处理浮游铜绿假单胞菌PAO1可使妥布霉素的疗效提高10倍,将MIC从0.75降至0.075 µg/mL。这些数据支持了将传统抗生素治疗与非抗生素化合物相结合以提高当前治疗效果的方法的有效性。